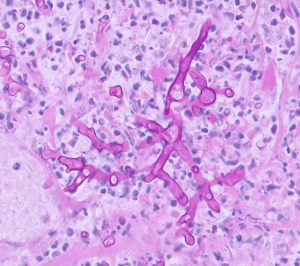
Fungal hyphae found in the wall of the abomasum

Email Us
admin@axiomvetlab.co.uk
Oncology Service Now Available – FREE for 3 months
Hello Colleagues
Our ordering platform is now closed, our sister company MiLab Diagnostics are now handling our consumable orders.
If you have not received an invite for their platform please visit milab.store and submit a request, please ensure you populate all the fields on the request form.
Thank you, Team Axiom.


https://www.facebook.com/Axiomfarmvetlab/
This newsletter is sent by e-mail to each vet practice but if you would like a copy sent to your individual e-mail account please contact us at dsfarm@axiomvetlab.co.uk and we can add you to our circulation list.
Would you like to send the Axiom farm vets photos of PMEs to allow us to assist with sample selection and diagnosis? Please send photos by WhatsApp to 07944 649222.
You may find this is a more efficient way of making requests than phoning the farm team, saving you time in your busy day. Our farm team also find it a more efficient way of dealing with your requests.
The email address for test requests is: dsfarm@axiomvetlab.co.uk
If you wish to speak to a particular farm vet about one of your cases, you can consult the table below to see when our vets are usually available. A duty farm veterinary advisor is always around on a Saturday morning from 9am-12pm.

As part of our continuing effort to help improve our services to clients within the Laboratory Division we have put together a short survey which will be sitting live permanently for anyone to complete whenever they have a few minutes spare. This can be filled in by anyone who uses any of our services and we encourage feedback to
help us understand what we are doing well and where we need to make improvements. The QR code and link to the survey will remain live as a continuous tool to enable us to always gather feedback. If anyone has any questions about this, they are welcome to contact either of the Quality Managers at the Laboratories, Claire
Richardson for Axiom Veterinary Laboratories and Susan Reeve for Finn Pathologists. Thank you in advance for helping us to improve our services.
https://www.surveymonkey.com/r/Laboratory_Satisfaction_Survey
We wish to remind vets that as a commercial laboratory we are unable to offer any Bluetongue testing either on blood samples or abortion material. If we receive samples from cases in which Bluetongue is suspected, we are required to safely dispose of the samples and cannot provide any further testing. We are always happy to discuss cases over the phone before submission of samples. Clinical suspicion of BTV infection must be reported to APHA. Further information on investigating poor reproductive performance in cattle and sheep during Bluetongue outbreaks can be found at the following link:
To maximise the chance of a diagnosis in abortion cases, foetal stomach content (FSC) is one of the most useful samples we can receive. It is used primarily to identify bacteriological and fungal causes of abortion. It is an important component of our abortion PCR package (Test code: FABORT) where it is used in a ‘pool’ along with fresh foetal brain and liver tissue. In a freshly aborted foetus, the abomasal contents will be relatively protected from environmental contamination as opposed to, for example, placental tissue which tends to be heavily contaminated. When sampling FSC the risk of contamination can be minimised by using a sterile vacutainer and needle punctured though the stomach wall to sample the fluid inside. Where insufficient fluid is present then an alternative is to nick the stomach wall with a clean scalpel and introduce a swab (charcoal or other swab with transport media suitable for bacteriology) through the wall to sample the contents. FSC is only suitable for testing in abortion cases and cases at term where the animal was known to have been stillborn. Stomach contents from animals that have been alive for several hours/ days are not suitable for testing as they may have received milk/milk replacers or attempted to suckle contaminating of the stomach contents and leading to less than useful results e.g detection of the agent in milk/colostrum.
Unfortunately, the Mastitis 16 pathogen PCR referral test is no longer available to us. As an alternative you may wish to consider the Mastitis Rapid Molecular test which is available at Axiom (Test code: FAMAS). This test detects the presence of six key mastitis pathogens, and the turnaround time is no longer than the following working day. This can allow a targeted course of treatment based upon the pathogens present, aiding responsible use of antibiotics and resulting in less discarded milk. As well as potentially saving money there are benefits for herd health in the long term. The agents detected are E. coli, Staphylococcus aureus, Streptococcus uberis, Streptococcus dysgalactiae, Streptococcus agalactiae and Klebsiella pneumoniae. The cost of the test is £45 & VAT (test code FAMAS).
Cattle
Abortions/mastitis
Respiratory disease

Figure 1: Lung tissue is near completely effaced by bright pink eosinophilic coagula (caseonecrotic material) in a calf with virulent Mycoplasmopsis bovis pneumonia.
Gastrointestinal disease
Figure 2 : Fungal hyphae found in the wall of the abomasum of a calf with abomasal ulceration (PAS stain)
Skin and eye disease

Figure 3: A cross-section of a penile fibropapilloma from a bull showing a proliferation of loosely packed mesenchymal cells, covered by a hyperplastic epithelium.
Systemic and miscellaneous disease
Abortions, reproductive disease, mastitis
Respiratory disease
Gastrointestinal disease
Skin and eye disease
Systemic and miscellaneous disease
https://www.facebook.com/Axiomfarmvetlab/
This newsletter is sent by e-mail to each vet practice but if you would like a copy sent to your individual e-mail account please contact us at dsfarm@axiomvetlab.co.uk and we can add you to our circulation list.
Farm May Newsletter 2026 Dedicated farm line – 01626 357776 Follow us on Facebook https://www.facebook.com/Axiomfarmvetlab/…
Farm March Newsletter 2026 Dedicated farm line – 01626 357776 Follow us on Facebook https://www.facebook.com/Axiomfarmvetlab/…
Download a PDF
Download a PDF
For receiving our news and updates in your inbox directly.

Manor House, Brunel Road, Newton Abbot, Devon, TQ12 4PB

The great explorer of the truth, the master-builder of human happiness no one rejects dislikes avoids pleasure itself because it is pleasure but because know who do not those how to pursue pleasures rationally encounter consequences that are extremely painful desires to obtain.
Read More



